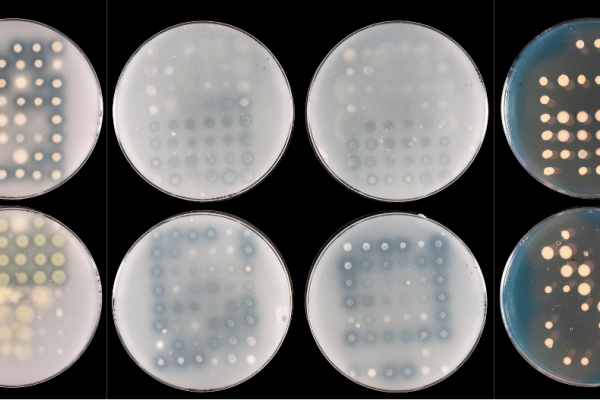

Con el reto de mejorar el rendimiento de los cultivos y reducir el impacto medioambiental
La iniciativa del TFI y otros organismos pretende acelerar el desarrollo de tecnologías innovadoras de fertilizantes y aumentar el uso de los actuales fertilizantes de eficiencia mejorada.
Con el reto de mejorar el rendimiento de los cultivos y reducir el impacto medioambiental Leer más »